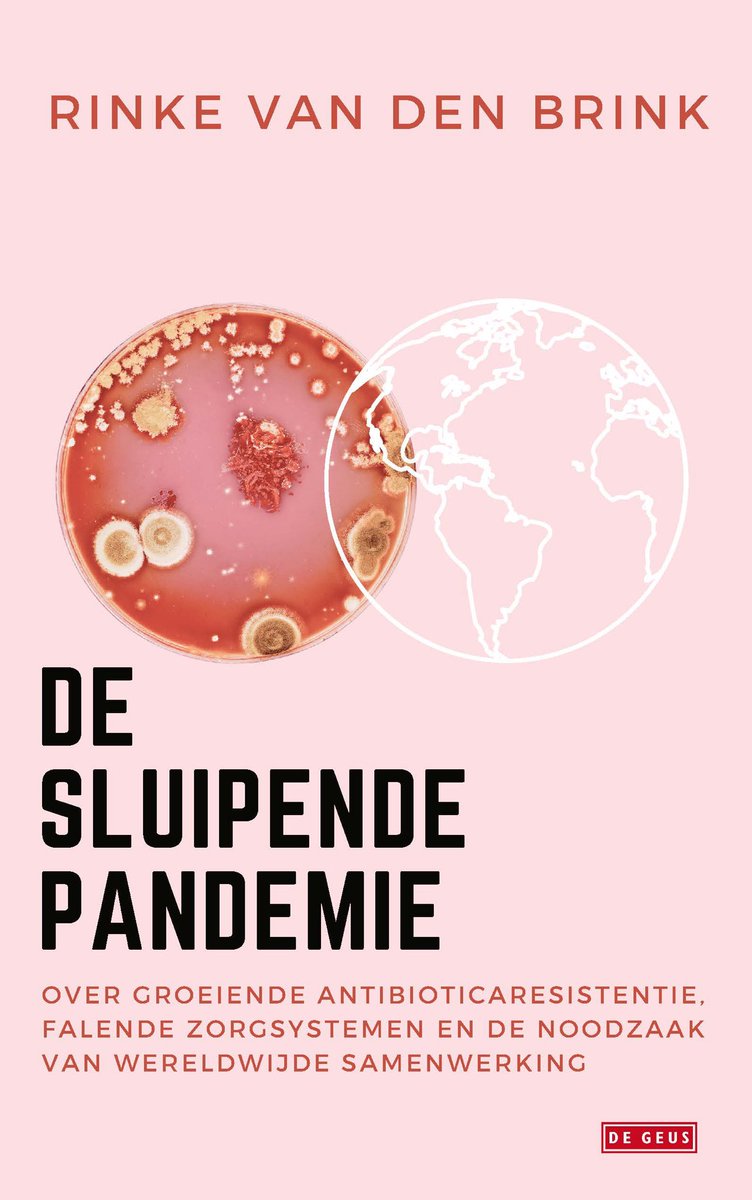

Rinke van den Brink
@rinkevdbrink
Health journalist. Books on bacteriophages(24) own sepsis&psychosis (20), antibiotic resistance (NL 13, Germ.15,Eng.21) & extr. right. Lectures?@Schrijverscentr
ID: 256000219
22-02-2011 13:08:49
16,16K Tweet
4,4K Followers
1,1K Following